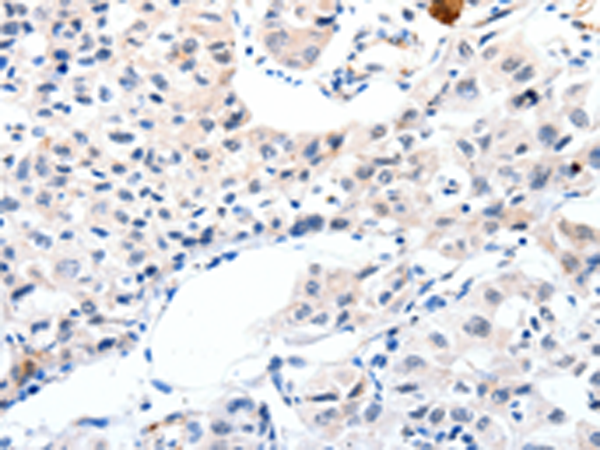
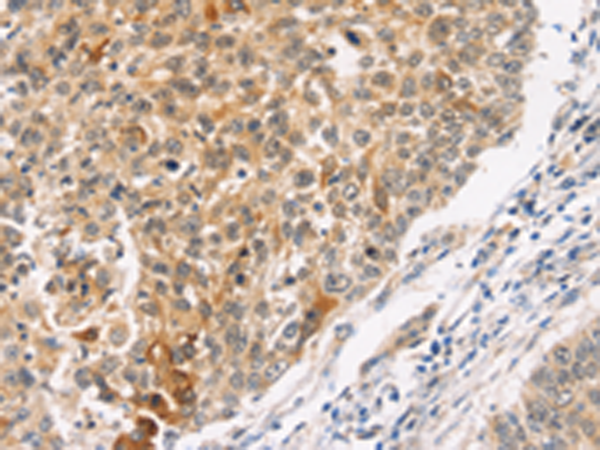

-
分类: 科研抗体货号: P10982别名: CKLF; IKLF; BTEB2应用: WB反应种属: Human, Mouse
-
分类: 科研抗体货号: P10966别名: IGFI, IGF-I, IGF1A应用: IHC反应种属: Human
-
分类: 科研抗体货号: P10976别名: IRS-2应用: IHC反应种属: Human, Mouse
-
分类: 科研抗体货号: P10981别名: HH13; KiSS-1应用: WB,IHC反应种属: Human, Mouse
-
分类: 科研抗体货号: P10965别名: AGM, PSF, TAF, FSTL2, IBP-7, MAC25, IGFBP-7, RAMSVPS, IGFBP-7v, IGFBPRP1应用: WB,IHC反应种属: Human, Mouse
-
分类: 科研抗体货号: P10975别名: HL9, ILT5, LIR3, PIRB, CD85A, ILT-5, LIR-3, LILRA6应用: IHC反应种属: Human
-
分类: 科研抗体货号: P10980别名: KIA; MIB-; MIB-1; PPP1R105应用: WB反应种属: Human
-
分类: 科研抗体货号: P10964别名: IBP3; BP-53应用: IHC反应种属: Human, Mouse, Rat
-
分类: 科研抗体货号: P10974别名: IMD39; IRF-7; IRF7A; IRF7B; IRF7C; IRF7H; IRF-7H应用: IHC反应种属: Human, Mouse
-
分类: 科研抗体货号: P10979别名: JNK2, SAPK, p54a, JNK2A, JNK2B, PRKM9, JNK-55, SAPK1a, JNK2BETA, p54aSAPK, JNK2ALPHA应用: WB,IHC反应种属: Human, Mouse, Rat

鄂公网安备42018502007531号
鄂公网安备42018502007531号

